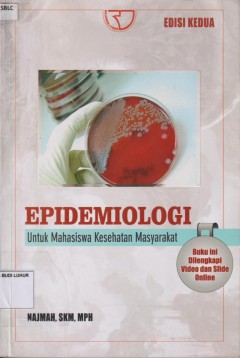
cover

Ditapis dengan
Ditemukan 4 dari pencarian Anda melalui kata kunci: subject="Epidemiology"

Epidemiologi HIV - AIDS
- Edisi
- -
- ISBN/ISSN
- 978-602-0946-66-5
- Deskripsi Fisik
- xii, 196 hlm.; 21 cm.
- Judul Seri
- -
- No. Panggil
- 616.9 KAT e
- Edisi
- -
- ISBN/ISSN
- 978-602-0946-66-5
- Deskripsi Fisik
- xii, 196 hlm.; 21 cm.
- Judul Seri
- -
- No. Panggil
- 616.9 KAT e

Epidemiologi untuk mahasiswa kesehatan masyarakat
- Edisi
- -
- ISBN/ISSN
- 978-602-425-052-2
- Deskripsi Fisik
- xxviii, 246 hlm.; 23 cm.
- Judul Seri
- -
- No. Panggil
- 616.9 NAJ e
- Edisi
- -
- ISBN/ISSN
- 978-602-425-052-2
- Deskripsi Fisik
- xxviii, 246 hlm.; 23 cm.
- Judul Seri
- -
- No. Panggil
- 616.9 NAJ e

Pengantar Epidemiologi
- Edisi
- -
- ISBN/ISSN
- 978-602-6322-92-0
- Deskripsi Fisik
- x, 210 hlm.; 26 cm.
- Judul Seri
- -
- No. Panggil
- 616.9 AKB h
- Edisi
- -
- ISBN/ISSN
- 978-602-6322-92-0
- Deskripsi Fisik
- x, 210 hlm.; 26 cm.
- Judul Seri
- -
- No. Panggil
- 616.9 AKB h
Epidemiologi & antropologi suatu pendekatan
- Edisi
- -
- ISBN/ISSN
- 978-602-1186-79-4
- Deskripsi Fisik
- x, 303 hlm.; 23 cm.
- Judul Seri
- -
- No. Panggil
- 301 LAP e
- Edisi
- -
- ISBN/ISSN
- 978-602-1186-79-4
- Deskripsi Fisik
- x, 303 hlm.; 23 cm.
- Judul Seri
- -
- No. Panggil
- 301 LAP e
 Karya Umum
Karya Umum  Filsafat
Filsafat  Agama
Agama  Ilmu-ilmu Sosial
Ilmu-ilmu Sosial  Bahasa
Bahasa  Ilmu-ilmu Murni
Ilmu-ilmu Murni  Ilmu-ilmu Terapan
Ilmu-ilmu Terapan  Kesenian, Hiburan, dan Olahraga
Kesenian, Hiburan, dan Olahraga  Kesusastraan
Kesusastraan  Geografi dan Sejarah
Geografi dan Sejarah